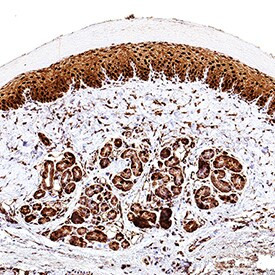
FABP5 Antibody in Immunohistochemistry (Paraffin) (IHC (P))

Search
Invitrogen
FABP5 Polyclonal Antibody
{{$productOrderCtrl.translations['antibody.pdp.commerceCard.promotion.promotions']}}
{{$productOrderCtrl.translations['antibody.pdp.commerceCard.promotion.viewpromo']}}
{{$productOrderCtrl.translations['antibody.pdp.commerceCard.promotion.promocode']}}: {{promo.promoCode}} {{promo.promoTitle}} {{promo.promoDescription}}. {{$productOrderCtrl.translations['antibody.pdp.commerceCard.promotion.learnmore']}}
图: 1 / 4
FABP5 Antibody (PA5-47143) in IHC (P)




产品信息
PA5-47143
种属反应
宿主/亚型
分类
类型
抗原
偶联物
形式
浓度
规格
纯化类型
保存液
内含物
保存条件
运输条件
RRID
产品详细信息
In Western blots, less than 5% cross-reactivity with recombinant mouse FABP4 and recombinant human (rh) FABP3 is observed and less than 1% cross-reactivity with recombinant rat (rr) FABP2 and rrFABP1 is observed.
Reconstitute at 0.2 mg/mL in sterile PBS.
靶标信息
FABP5 (fatty acid binding protein 5 (psoriasis-associated)) is a proteinthat in humans is encoded by theFABP5 gene, also known as PAFABP, EFABP, E-FABP, KFABP, PA-FABP, Epidermal-type fatty acid-binding protein, Fatty acid-binding protein 5, Psoriasis-associated fatty acid-binding protein homolog. It is a family of small, highly conserved, cytoplasmic proteins that bind long-chain fatty acids and other hydrophobic ligands. The PAFABP cDNA encodes a 135-amino acid protein with molecular weight 15,164. This gene encodes the fatty acid binding protein found in epidermal cells, and was first identified as being upregulated inpsoriasistissue. It is though that FABPs roles include fatty acid uptake, transport, and metabolism. Kaczocha et al. (2009) identifiedFABP5and FABP7 as cytosolic proteins that transport AEA from the plasma membrane to subcellular fatty acid amide hydrolase, where it is hydrolyzed and inactivated. FABP3 did not show this specific transport function.
仅用于科研。不用于诊断过程。未经明确授权不得转售。
篇参考文献 (0)
生物信息学
蛋白别名: C-FABP; Cutaneous fatty acid-binding protein; DA11; E-FABP; E-FABPPAFABP; Epidermal-type fatty acid-binding protein; epithelial fatty acid-binding protein; fatty acid binding protein 5 (psoriasis-associated); Fatty acid-binding protein 5; Fatty acid-binding protein, epidermal; Keratinocyte lipid-binding protein; PA-FABP; PA-FABPepidermal; Psoriasis-associated fatty acid-binding protein homolog; unnamed protein product
基因别名: C-FABP; DA11; E-FABP; EFABP; FABP5; Fabpe; KFABP; Klbp; Mal1; PA-FABP; PAFABP
UniProt ID: (Human) Q01469, (Rat) P55053, (Mouse) Q05816
Entrez Gene ID: (Human) 2171, (Rat) 140868, (Mouse) 16592